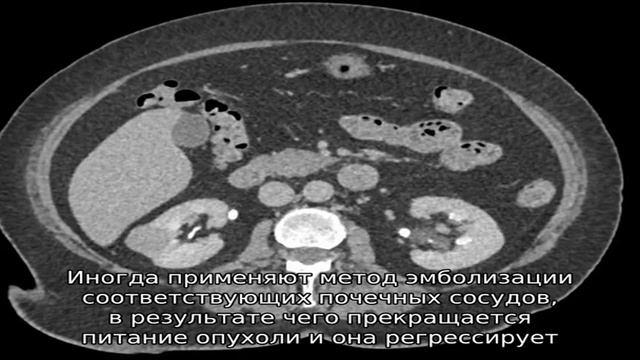
Аденома почки смотреть онлайн

Автор: Таинственный вопрос Страница 4

Пермяков Иван чуцзи наньцюань группа Б 1 место

Как сделать так чтобы засохший лёгкий пластилин обратно лепил

Топ Стример ● Охота На Американца TS-5 Будет Жарко ● Первый День Марафона ● Буду Рад Всех Видеть

Срочно в номер!!!

Как поменять игровой режим в minecraft pe

Xiaomi mi stick

Блогер - снимай и показывай. Тот момент, когда ты хочешь сдаться справедливость не в твой адресс.

Как правильно делать планку.

Расскажи о себе?🤭 Да всё как у людей.🤗😍 Галина Фи.🤓🤗

Кто думал что будет легко?! Идем дальше

Полное замещение диска

Зомби Ферма - Zombie Farm - 🎁 Мыльная Опера 🎁 - 🎆 🎆 🎆 Прохождение Квеста Утомили!. 🎆 🎆 🎆
Аденома почки

как писать историческое сочинение

cs:go лол : )

Подарки старикам

Всем добрый день, учли все недочёты, всем добра.

Значит это кукуруза | 13 А и ЧувствоЗнание

A4 | Memphis Jooking на Красной Площади | #БУДЬВКОНТРАСТЕ

|Pandora Hearts| У них нет мозга

Мастерская радости

Перед покупкой недвижимости в Турции обязательно посмотрите это видео!

Аргентина Колумбия. Argentina Vs Colombia 0 0 Penalties 5 4 All Goals Highlights Copa America 2015

Девочка, которой хотелось бы иметь ваши возможности
За каждым успешным каналом стоит личность, идея и сотни часов кропотливого труда. Если вы здесь, значит, автор «Таинственный вопрос» уже сумел зацепить ваше внимание своим уникальным стилем или подачей. А мы на RUVIDEO позаботились о том, чтобы вы могли изучить весь архив его работ в максимально комфортных условиях — без лишней суеты и преград.
Почему за работами канала «Таинственный вопрос» так интересно наблюдать? Всё просто: это честный контент, который находит отклик в сердцах зрителей. На нашем ресурсе вы можете смотреть онлайн все видео любимого автора бесплатно и в хорошем качестве. Нам важно, чтобы вы видели каждую деталь и слышали каждый нюанс, поэтому мы используем только стабильные плееры из открытых источников Rutube.
Следите за новинками канала, пересматривайте старые шедевры и открывайте для себя новые грани творчества «Таинственный вопрос». Мы постоянно обновляем ленту, чтобы у вас под рукой всегда были самые свежие выпуски. Никаких сложных регистраций — только вы и творчество, которое вдохновляет. Приятного вам путешествия по миру авторского контента на RUVIDEO!
Видео взято из открытых источников Rutube. Если вы правообладатель, обратитесь к первоисточнику.